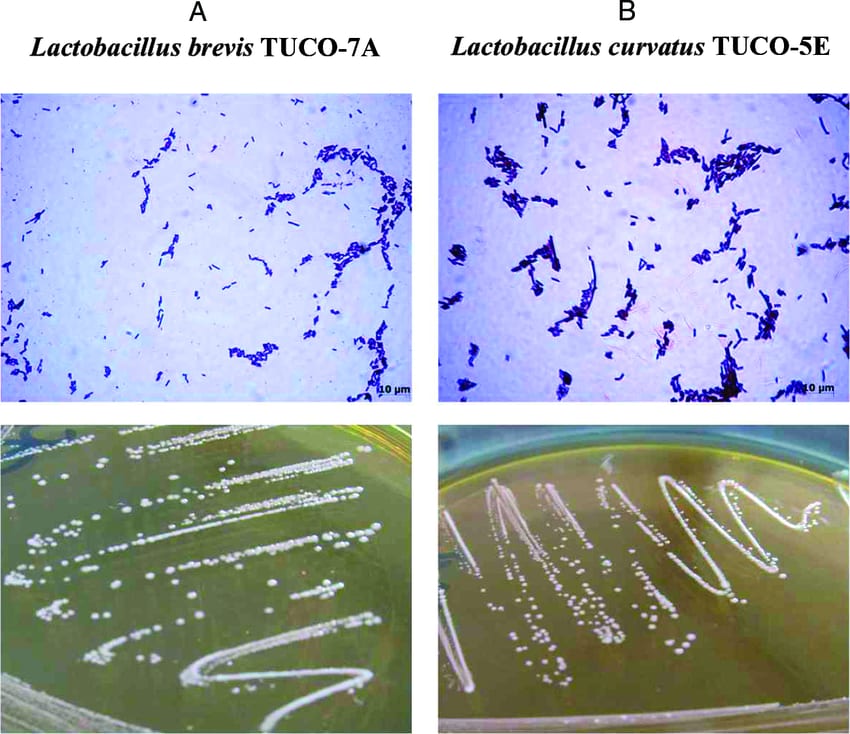

Hoạt Chất Lactobacillus brevis W63: Lợi Ích và Ứng Dụng Trong Sức Khỏe
Giới thiệu về Lactobacillus brevis W63

Lactobacillus brevis W63 là một chủng vi khuẩn lợi khuẩn (probiotic) thuộc loài Levilactobacillus brevis (trước đây được phân loại là Lactobacillus brevis trước khi chi Lactobacillus được chia thành 25 chi mới vào năm 2020). Chủng W63 được nghiên cứu nhờ khả năng hỗ trợ sức khỏe đường ruột, tăng cường miễn dịch và giảm nguy cơ nhiễm trùng đường hô hấp trên (URTI). Được sử dụng trong các sản phẩm thực phẩm chức năng và chế phẩm lên men, Lactobacillus brevis W63 nổi bật với khả năng sống sót trong môi trường khắc nghiệt của dạ dày, mang lại nhiều lợi ích cho sức khỏe con người và động vật.
Trong bối cảnh ngày càng nhiều người quan tâm đến lợi khuẩn và sức khỏe tiêu hóa, Lactobacillus brevis W63 đang thu hút sự chú ý nhờ các đặc tính sinh học vượt trội, bao gồm sản xuất axit lactic, hydrogen peroxide, và bacteriocin, giúp ức chế vi khuẩn gây bệnh. Bài viết này sẽ cung cấp cái nhìn toàn diện về hoạt chất này, từ đặc điểm, lợi ích, đến ứng dụng thực tiễn.
Lactobacillus brevis W63 là gì?
Lactobacillus brevis W63 là một chủng cụ thể của loài Levilactobacillus brevis, một loại vi khuẩn Gram dương, kỵ khí tùy tiện, hình que, thuộc nhóm vi khuẩn axit lactic (LAB). Chủng W63 được phân lập để sử dụng trong các công thức probiotic đa chủng, thường kết hợp với các vi khuẩn khác như Bifidobacterium bifidum W23, Lactobacillus acidophilus W22, và Lactococcus lactis W58. Vi khuẩn này có khả năng bám dính vào niêm mạc ruột, sản xuất các hợp chất kháng khuẩn, và hỗ trợ cân bằng hệ vi sinh đường ruột.
Đặc điểm của Lactobacillus brevis W63
- Tính chất sinh học: Sản xuất axit lactic, hydrogen peroxide, và bacteriocin, giúp ức chế vi khuẩn có hại như Escherichia coli, Listeria monocytogenes, và Salmonella.
- Khả năng sống sót: W63 chịu được môi trường axit dạ dày (pH 2–3) và dịch mật (0.3–1%), đảm bảo đến được ruột để phát huy tác dụng.
- Tính an toàn: Được công nhận là an toàn (GRAS) bởi FDA, phù hợp cho trẻ em, người lớn, và phụ nữ mang thai khi sử dụng đúng liều.
- Công nghệ bảo vệ: Thường được bao vi nang hoặc đông khô để bảo vệ vi khuẩn khỏi bị phá hủy trong quá trình tiêu hóa.
Phân loại và dạng sử dụng
Lactobacillus brevis W63 được sử dụng dưới nhiều dạng, tùy thuộc vào mục đích:
- Dạng bột: Thêm vào sữa bột, thực phẩm chức năng, hoặc thức ăn chăn nuôi.
- Dạng viên nang: Sử dụng trong các sản phẩm bổ sung probiotic cho người lớn và trẻ em.
- Dạng dung dịch: Có trong sữa chua, đồ uống lên men như kefir, hoặc các chế phẩm lỏng.
- Dạng gói: Dễ sử dụng cho trẻ sơ sinh hoặc người lớn tuổi, thường kết hợp với các chủng lợi khuẩn khác.
Ứng dụng của Lactobacillus brevis W63 trong đời sống
Lactobacillus brevis W63 được ứng dụng rộng rãi trong y học, dinh dưỡng, và chăn nuôi nhờ khả năng cải thiện hệ vi sinh đường ruột và tăng cường sức khỏe. Dưới đây là các ứng dụng nổi bật:
1. Trong dinh dưỡng và sức khỏe
Lactobacillus brevis W63 là thành phần quan trọng trong các sản phẩm probiotic, mang lại nhiều lợi ích cho sức khỏe tiêu hóa và miễn dịch.
- Cải thiện sức khỏe đường ruột: W63 sản xuất axit lactic và bacteriocin, giúp cân bằng hệ vi sinh, ức chế vi khuẩn gây bệnh, và giảm viêm ruột.
- Hỗ trợ điều trị tiêu chảy: Giúp giảm tiêu chảy liên quan đến kháng sinh (AAD) bằng cách khôi phục vi khuẩn có lợi bị mất do sử dụng kháng sinh.
- Hội chứng ruột kích thích (IBS): Giảm các triệu chứng như đau bụng, đầy hơi, và rối loạn nhu động ruột ở người bị IBS.
- Tăng cường miễn dịch: Kích thích sản xuất kháng thể IgA và mucin, bảo vệ niêm mạc ruột và tăng sức đề kháng chống nhiễm trùng, đặc biệt là URTI như cảm lạnh và cúm.
- Hỗ trợ tiêu hóa lactose: Sản xuất enzyme β-galactosidase, giúp phân hủy lactose, phù hợp cho người không dung nạp lactose.
2. Trong thực phẩm chức năng
- Sữa chua và đồ uống lên men: W63 được thêm vào sữa chua, kefir, hoặc đồ uống probiotic để tăng cường lợi khuẩn, hỗ trợ tiêu hóa.
- Bột sữa trẻ em: Được sử dụng trong sữa bột để thiết lập hệ vi sinh đường ruột khỏe mạnh ở trẻ sơ sinh.
- Thực phẩm bổ sung: Có trong viên nén, gói bột, hoặc thanh năng lượng dành cho người lớn tuổi hoặc người có rối loạn tiêu hóa.
3. Trong dược phẩm
- Hỗ trợ điều trị nhiễm trùng: W63 được sử dụng kết hợp với kháng sinh để tăng hiệu quả diệt trừ vi khuẩn Helicobacter pylori, nguyên nhân gây loét dạ dày.
- Thuốc bổ sung probiotic: Giúp khôi phục vi khuẩn có lợi sau khi sử dụng kháng sinh hoặc hóa trị liệu.
- Hỗ trợ viêm loét đại tràng: W63 giúp giảm viêm và cải thiện triệu chứng ở người bị viêm loét đại tràng hoặc bệnh Crohn.
4. Trong chăn nuôi và nuôi trồng thủy sản
- Thức ăn chăn nuôi: W63 được thêm vào thức ăn gia súc, gia cầm để cải thiện tiêu hóa, tăng trưởng, và giảm sử dụng kháng sinh.
- Lên men thực phẩm: Sử dụng trong lên men rơm, bột đậu nành, hoặc các sản phẩm chăn nuôi để tăng giá trị dinh dưỡng.
5. Trong chăm sóc mẹ và bé
- Phụ nữ mang thai: Bổ sung W63 giúp cải thiện tiêu hóa ở mẹ và giảm nguy cơ dị ứng, eczema ở trẻ sơ sinh.
- Trẻ sơ sinh: W63 hỗ trợ thiết lập hệ vi sinh đường ruột từ sớm, giảm nguy cơ tiêu chảy và viêm da cơ địa.
Lợi ích của việc sử dụng Lactobacillus brevis W63
Sử dụng Lactobacillus brevis W63 mang lại nhiều lợi ích vượt trội:
- Hỗ trợ tiêu hóa: Cải thiện tiêu hóa carbohydrate phức tạp, giảm đầy hơi, táo bón, và tiêu chảy.
- Tăng cường miễn dịch: Kích thích hoạt động của tế bào NK (natural killer), tăng sức đề kháng chống nhiễm trùng đường hô hấp trên.
- An toàn cho mọi lứa tuổi: Phù hợp cho trẻ sơ sinh, người lớn, và người cao tuổi khi sử dụng đúng liều.
- Kháng khuẩn tự nhiên: Sản xuất hydrogen peroxide và bacteriocin, ức chế vi khuẩn gây bệnh như Streptococcus mutans (gây sâu răng).
- Hỗ trợ sức khỏe tâm lý: Một số nghiên cứu cho thấy lợi khuẩn như L. brevis có tiềm năng cải thiện tâm trạng và giảm stress thông qua trục ruột-não.
Thách thức và lưu ý khi sử dụng Lactobacillus brevis W63
Mặc dù có nhiều lợi ích, việc sử dụng W63 cần được thực hiện cẩn thận:
- Tác dụng phụ: Có thể gây đầy hơi, khó chịu đường ruột ở một số người, đặc biệt khi bắt đầu sử dụng hoặc dùng liều cao.
- Hệ miễn dịch yếu: Người có hệ miễn dịch suy yếu (như bệnh nhân HIV/AIDS hoặc đang hóa trị) cần tham khảo bác sĩ trước khi sử dụng do nguy cơ nhiễm trùng hiếm gặp.
- Liều lượng: Liều khuyến nghị thường từ 1-10 tỷ CFU/ngày, tùy thuộc vào sản phẩm và tình trạng sức khỏe. Không có liều chuẩn chung.
- Bảo quản: Cần bảo quản ở nhiệt độ phòng hoặc tủ lạnh theo hướng dẫn để đảm bảo vi khuẩn sống sót.
- Dị ứng: Tránh sử dụng ở người dị ứng với bất kỳ thành phần nào trong sản phẩm chứa W63.
Các nghiên cứu gần đây về Lactobacillus brevis W63
Các nghiên cứu gần đây đã làm sáng tỏ tiềm năng của Lactobacillus brevis W63 trong sức khỏe con người:
- Hỗ trợ miễn dịch: Một nghiên cứu cho thấy công thức probiotic chứa L. brevis W63, cùng với Bifidobacterium bifidum W23 và Lactobacillus acidophilus W22, giúp tăng hoạt động tế bào NK và giảm nguy cơ URTI ở trẻ em, người già, và vận động viên.
- Kháng khuẩn: W63 thể hiện khả năng ức chế các vi khuẩn gây bệnh như Listeria monocytogenes và Escherichia coli nhờ sản xuất bacteriocin và hydrogen peroxide.
- Ứng dụng trong thực phẩm: W63 được sử dụng trong các sản phẩm lên men như sữa chua và kefir, tăng cường giá trị dinh dưỡng và an toàn thực phẩm.
- Từ khóa chính: Lactobacillus brevis W63, lợi khuẩn W63, probiotic W63.
- Từ khóa phụ: Lợi khuẩn đường ruột, sức khỏe tiêu hóa, men vi sinh W63, thực phẩm chức năng probiotic.
Kết luận
Lactobacillus brevis W63 là một lợi khuẩn mạnh mẽ, mang lại lợi ích to lớn cho sức khỏe tiêu hóa, miễn dịch, và tổng thể. Từ việc hỗ trợ trẻ sơ sinh thiết lập hệ vi sinh đến cải thiện rối loạn tiêu hóa ở người lớn, W63 đã chứng minh giá trị trong thực phẩm chức năng, dược phẩm, và chăn nuôi. Tuy nhiên, cần sử dụng đúng liều lượng và tham khảo ý kiến bác sĩ, đặc biệt với những người có hệ miễn dịch yếu.
Hãy tiếp tục theo dõi các bài viết của chúng tôi để cập nhật thêm thông tin về lợi khuẩn và sức khỏe. Nếu bạn có câu hỏi hoặc muốn chia sẻ kinh nghiệm sử dụng Lactobacillus brevis W63, hãy để lại bình luận bên dưới!